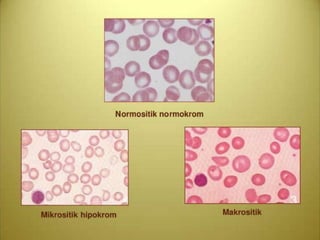

Anemia adalah kondisi di mana kadar hemoglobin dan jumlah eritrosit di dalam darah tidak mencukupi untuk memenuhi kebutuhan oksigen tubuh. Penyebabnya bervariasi, termasuk defisiensi zat besi, vitamin B12, dan asam folat, serta faktor genetik dan penyakit kronis. Penatalaksanaannya tergantung pada jenis dan penyebab anemia, mencakup terapi kausal, dukungan transfusi, dan suplemen nutrisi.